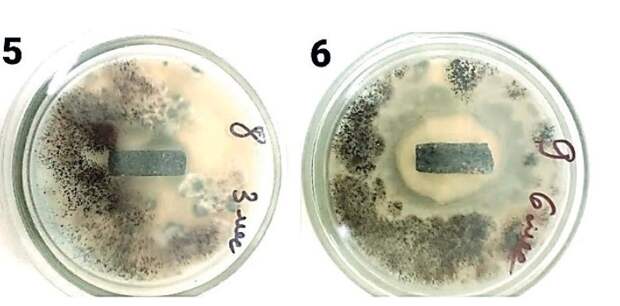

Ученые ННГУ определили, как защитить от грибка и плесени цемент, бетон и гипс. Работу провели совместно с исследователями из Пермского политеха и Мордовского университета им. Огарева, рассказал сотрудник пресс-службы вуза Алексей Никонов в соцсетях. В исследовании использовали отечественное вещество — биоцид полигексаметиленгуанидин гидрохлорид (или ПГМГ-ГХ), добавив его в цемент, бетон и гипс.
Раньше его применяли в лаках и красках для защиты дерева от микроорганизмов.Пермские ученые напечатали на 3D-принтере формы, в которые залили растворы гипсовой штукатурки, бетона и цементного камня, и в некоторые из них добавили биоцид. Затем эти образцы заразили спорами плесневых грибов. Там, где было названное вещество, плесень больше не росла.
«А это значит, что все фасады и строительные конструкции будут служить гораздо дольше, сохраняя первозданный эстетический облик», — пояснил Никонов.
Ранее на сайте pravda-nn.ru сообщалось, что нижегородские ученые пересмотрели понятие старения.
Свежие комментарии